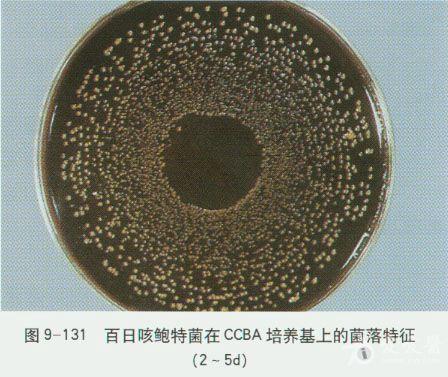
微生物图谱之g小杆菌

鲍金培养基

牛脑浸粉beefbraininfusion
图片尺寸1666x2246
微生物图谱之g小杆菌
图片尺寸448x377
溏心皇金鲍,好吃的干鲍,美味诱人
图片尺寸6720x4480
图绘经典巨著传播真理力量资本论绘本当代价值研讨会在上海交大召开
图片尺寸800x533
潮汕_金成_大明
图片尺寸2624x3936
全部图片
图片尺寸670x447
陆家嘴正大工作日老板请客,感受鲍鸡煲鲍金两这家店
图片尺寸1080x720
儿童诗丨梦想
图片尺寸640x1535
顺景花园酒店
图片尺寸4032x3024
2 初次分离营养要求高,选用在鲍金培养基或ccba培养基 布鲁菌
图片尺寸455x454
钱会文化(5)班聚会
图片尺寸1500x1893
皇金鲍
图片尺寸5184x3456
526michael的饭盒子
图片尺寸1080x908
名城金控集团董事长鲍金林先生(右二)及访问团成员
图片尺寸1080x810![[党史学习教育]上海交大鲍金做客市委网信办迎接建党](https://i.ecywang.com/upload/1/img1.baidu.com/it/u=2554925475,1977673110&fm=253&fmt=auto&app=138&f=JPEG?w=750&h=500)
[党史学习教育]上海交大鲍金做客市委网信办迎接建党
图片尺寸800x533
河山沦陷 歌姬捐献陪酒钱 抗战时期澳门四界救灾会力
图片尺寸540x359
学院领导与哥斯达斯·尼哥兰多纳基斯教授合影(从左到右:鲍金副院长
图片尺寸641x428
财务部招标办党支部召开党史学习教育专题组织生活会
图片尺寸1269x846
兔年夜饭菜单大全_时令_清蒸石斑鱼_田园
图片尺寸1080x1620
鲍金
图片尺寸250x375











![[党史学习教育]上海交大鲍金做客市委网信办迎接建党](https://i.ecywang.com/upload/1/img1.baidu.com/it/u=2554925475,1977673110&fm=253&fmt=auto&app=138&f=JPEG?w=750&h=500)

![[党史学习教育]上海交大鲍金做客市委网信办迎接建党](https://news.sjtu.edu.cn/resource/upload/202104/20210401_011944_234.jpg)




